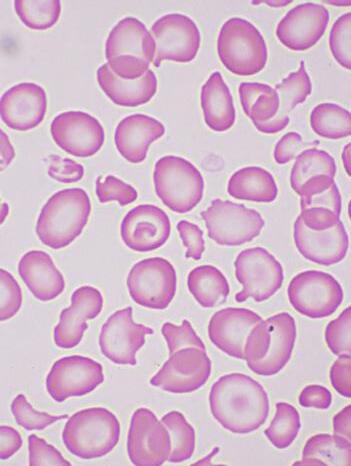

Dra. Rocío Rivas Bautista
Enfoque Snoezelen en el Autismo
Dra. Yvette Neme Yunes
Anemia por Deficiencia de Hierro
Dr. Isaac Rozen Fuller
Cirugía Plástica Estética
Dra. Rocío C. Grajales Álvarez
G8 Como Herramienta De Tamizaje
Essilor Luxottica
Grupo Clínico Proyecto Control Miopía
Ana Karen Díaz Martínez
Directora
Andrea Hernández
Directora De Mercadotecnia
Esther Jasso Mendoza
Directora Comercial
José Manuel Zurita Director Editorial
EN NUESTRAS REDES SOCIALES
Revista Solución Médica
revista.solucionmedica

REVISTASOLUCIONMEDICA.COM
Solución Médica ¡SUSCRÍBETE A NUESTRA REVISTA DIGITAL!
Imprenta: Grupo Editorial DM México, S.A. de C.V., Dirección: Periférico 4349, LOC 4-12, Tlalpan, 14210. Número de Reserva al Título ante el Instituto Nacional del Derecho de Autor: 04-2023-080310203300-102
Título incorporado en el Padrón Nacional de Medios Impresos de la Secretaría de Gobernación. Queda prohibida la reproducción parcial o total, modificación, distribución, transmisión, re-publicación, exhibición o ejecución de lo contenido en esta obra, incluyendo cualquier medio sin la debida autorización por escrita de Grupo Editorial DM México, S.A. de C.V., en términos de la legislación autoral y, en su caso, de los tratados internacionales aplicables, la persona que infrinja esta disposición se hará acreedora a las sanciones correspondientes. El contenido de los artículos, así como de los anunciantes y proveedores refleja única y exclusivamente el punto de vista de su autor. Los contenidos, promociones y materiales de los mismos son responsabilidad de su autor. Todos los materiales publicitarios que contengan alguna imagen o material que requiera de alguna licencia, serán responsabilidad de su autor o de la empresa anunciada. Grupo Editorial DM México, S.A. de C.V. se deslinda de cualquier responsabilidad en los materiales publicitarios elaborados por las distintas marcas que aparecen en esta publicación. Todos los nombres, marcas, diseños, fotografías, etc. Registrados o no, propias o de terceros son responsabilidad del anunciante.
Hecho en México. Esta revista utiliza tipografías Sofia Sans y Zilla Slab diseñadas para una mejor lectura.








Los lentes Essilor® Stellest™ ralentizan la progresión de la miopía en promedio, en un 67 %** en comparación con los lentes monofocales, cuando se usan 12 horas al día.


¿Desde cuándo se habla en el ambiente profesional de control de la miopía?
Desde el comienzo de la década de los 80’s del siglo XX, nos hemos encontrado con estudios muy representativos que marcan la historia de su evolución con estudios como el realizado por Garrec et al. en 19821; Leung & Brown en 19992; COMET en 20043 y Cheng et al. en 20124, e incluso actualmente y aún con mayor auge, algunos publicados como los de Bao et al en 20215 y en 20226. Hoy en día, nos encontramos cientos de conferencias y estudios procedentes de diferentes geografías que con muestras de pacientes y de ensayos clínicos controlados, evidencian que, si se puede lograr de alguna manera ralentizar el progreso de la miopía, en los niños y jóvenes, a través de diferentes e innovadoras formas de trabajo clínico profesional. Algunos de esos tratamientos ópticos han evolucionado tanto que como es el caso de los anteojos oftálmicos contamos con la cuarta generación categorizada para este fin. Principalmente y lo que más preocupa a los profesionales e investigadores es evitar que la miopía progrese tanto en valor refractivo como en tamaño del eje anteroposterior del ojo, en la comunidad infantil, buscando evitar que haya efectos secundarios o posteriores, con posibles patologías del ojo del adulto, que incluso llevan a discapacidad visual y cambian el futuro productivo de un paciente7
¿Por qué hay una tendencia a nivel mundial para aprender de control de miopía, y por qué se le refiere como una nueva pandemia?
Existe un estudio donde se muestra la prevalencia mundial de la miopía, alta miopía y, las tendencias temporales desde el año 2000 hasta el 2050, llevado a cabo por el equipo de investigadores del Instituto de Visión Brien Holden8, donde se incluyeron datos que abarcan 2.1 millones de participantes. Se estimó que para el año 2000, habrá 1,406 millones de personas con miopía (22.9% de la población mundial; 932-1932 millones [15,2 %-31,5 %]) y 163 millones de personas con miopía alta (2,7 % de la población mundial; 86-387 millones [1,4%-6,3%]). Prediciendo que para el 2030 habrá 4,758 millones de personas con miopía 49,8% de la población mundial; 3,620-6,056 millones [43,4% -55,7%]) y 938 millones de personas con miopía alta (9,8% de la población mundial; 479-2,104 millones [5,7%-19,4%]).
Comparando estas estimaciones sobre la miopía y la miopía alta del 2000 al 2050 sugieren aumentos significativos en la prevalencia a nivel mundial, mostrando implicaciones en los servicios de planificación, incluyendo el manejo y prevención de las complicaciones oculares relacionadas con la miopía, al igual que la pérdida de la visión entre casi mil millones de personas que presenta miopía alta.
De acuerdo con el doctor Kovin Naidoo, vicepresidente senior de impacto social para África y América Latina de la compañía Essilor, menciona en el blog: “La miopía, un desafío de salud pública que exige el liderazgo de la optometría” publicado en la página de la agencia internacional para la prevención de la ceguera (IAPB),9 la respuesta a este desafío de salud pública debe ser liderada por la Optometría, ya que tiene los servicios refractivos como un aspecto central de su alcance y que necesita un enfoque polifacético, que contiene los siguientes aspectos a considerar (e incluir a los oftalmólogos, desde su perspectiva profesional):
• Concienciación: El tiempo al aire libre se considera una prevención eficaz de la aparición y progresión de la miopía, y por ello es necesario acelerar los esfuerzos de promoción de la salud en todo el mundo.
• Investigación: Los investigadores de la industria, la optometría y la oftalmología han respondido a este desafío de crear lentes oftálmicos y lentes de contacto para el control de la miopía.
• Recursos Humanos: Este es un desafío constante para la profesión. Es urgente que los servicios profesionales de la visión estén a disposición de los niños en todas las regiones del mundo.
• Integración: La respuesta de la optometría y de la oftalmología a la miopía debe integrarse con la educación, la salud visual y ocular y los sistemas de salud.

• Promoción y cambio de políticas: La optometría y la oftalmología deben liderar los esfuerzos para garantizar que exista una política nacional que obligue al sistema de salud a proporcionar exámenes de la vista a todos los niños que ingresan a la escuela.
Debido a esto, no debemos descartar los esfuerzos interdisciplinarios, que puedan realizar los profesionales de la visión, al enfrentar esta situación de salud pública, mencionado el importante papel del licenciado en optometría, el oftalmólogo, el médico general y los terapeutas visuales, quienes en conjunto, tienen a cargo el educar a la comunidad sobre los potenciales riesgos que tiene un niño miope si no se atiende con corrección y control de progreso de su defecto visual por pequeño que este sea.10
Evidentemente el llamado no es, solo a “corregir la miopía, como defecto visual.” ¿Qué más debe incluirse en esta campaña de concientización?
Se ha investigado el potencial en el control de la miopía de los distintos métodos existentes, como lentes bifocales, lentes progresivas y lentes de contacto especiales en diferentes estilos de adaptaciones, antagonistas muscarínicos selectivos y no selectivos, agentes reductores de la presión intraocular, y lentes de contacto para el remodelado corneal.11
Sin embargo, hoy día, dentro del mercado mundial las opciones de corrección y control de la miopía con lentes oftálmicos en anteojos ya están disponibles, y después de muchos análisis se ha podido establecer que en esta categoría de corrección óptica con lentes oftálmicos, tenemos tres grupos emergentes en términos de eficacia.
Tenemos los mejores tratamientos, que son la nueva generación de lentes para anteojos que controlan la miopía (lentes oftálmicos con tecnologías desarrolladas para corregir y controlar la miopía). Están los lentes graduados bifocales y bifocales prismáticos en siguiente nivel de eficacia, al medio, y la tercera de las opciones, que podría ser la menos efectiva, los lentes graduados de adición progresiva y lentes de desenfoque periférico.12
Como se mencionó anteriormente, NO es suficiente con un tratamiento óptico, sin una serie de condiciones que aseguren el mantenimiento de la higiene visual y de la visión binocular. En sentido estricto, el control de la miopía, requiere de una muy buena refracción, la medición de la longitud axial ocular, la evaluación anual del fondo de ojo del niño miope, y algunas recomendaciones profilácticas de regularización de las actividades de día a día, tales como son: aumento del tiempo de actividades al aire libre relajando la visión cercana; reducción del tiempo de trabajo en visión cercana fuera de horas escolares, cuidado y reducción del tiempo en pantallas digitales, y hacer pausas activas de descanso al dedicar tareas visuales cercanas de tiempo prolongado. Sumado al control de uso permanente de anteojos o cualquier otra opción para control de la miopía.13, 14
Los principales objetivos en relación a la miopía según el World Council of Optometry (WCO)15 deben estar centrados en: Mitigar, medir y manejar.
¿Qué debemos hacer los profesionales de la visión para sumarnos a este nuevo desafío de la clínica, el cual rompe esquemas tradicionales de trabajo?
Los doctores. Kate y Paul Gifford de la plataforma virtual MyopiaProfile.com aciertan en invitar a todos los involucrados en el trabajo clínico con niños, a seguir estos tres simples consejos.16
1. Comenzar con una conversación: Considerar la corrección óptica, después de una muy buena refracción, teniendo cuidado de no hipo o hipercorregir, y dar los siguientes pasos en su propio aprendizaje, sobre cómo controlar el NO progreso de ese defecto corregido, según sea el caso. Hay que tener en cuenta que, cada caso es único y cada condición es diferente, pero no basta sólo con corregir y lograr una buena agudeza visual, por el contrario, es importante ver la integración saludable del estado visual y ocular y sobre todo la visión binocular.
2. Las consecuencias de la miopía a corto, como a largo plazo y, los beneficios del tratamiento deben explicarse a los padres en tres pasos: el “qué”, el “por qué” y el “cómo” del procedimiento del control miopía. Esto indica que cualquiera que sea la decisión que se tome sobre el tipo de tratamiento de control de miopía, se debe pacientemente clí-
Referencias:
nica y profesionalmente, hablar de los efectos de corto, mediano y largo plazo, de la efectividad del mismo, y a la vez, explicar los efectos del incumplimiento del mismo. La tarea es compleja ya que, hay que simular el futuro visual y ocular del niño 20 años y 30 años más adelante a ese momento actual.
3. Es importante combinar una mejor educación de los profesionales de la visión con una mayor conciencia pública, siendo capaces de ver el cambio real que el mundo necesita, cambiando la trayectoria de la miopía. Con urgencia hay que hacer un llamado mundial, para que la actualización académica y de los protocolos clínicos de trabajo sobre la miopía se realicen en cada país del mundo, para que no sólo desde la clínica curativa y terapéutica se trabaje en esta campaña, sino desde la política pública, desde la promoción y prevención en ambientes escolares, y en la conciencia general de la población actual, poniendo mayor énfasis en los miopes que heredarán, probablemente su defecto a nuevas generaciones: hijos y nietos.
Y como lo menciona la Dra. Kate Gifford en sus presentaciones sobre control de la miopía, “Todo lo que hacemos para resistir a la progresión de la miopía es importante para nuestros jóvenes miopes de hoy, así como para nuestros adultos del mañana” , lo cual no va a suceder en nuestro entorno profesional, si no desafiamos los pensamientos tradicionales de la terapéutica correctiva en miopía, que aprendimos en la escuela clásica, y que además estamos tardándonos en actualizar y comenzar a proponer nuevas estrategias activas cambiando de protocolos y evidencia de resultados. Tenemos todo para lograrlo, lo importante es comenzar a ello.
*Nota: Este artículo de la categoría control miopía es el resultado del trabajo conjunto e interdisciplinario de los siguientes profesionales de la visión, que lideran el Proyecto Control Miopía de la compañía EssilorLuxottica en México:
• Cárdenas Lamas, Luis Javier. Oftalmólogo.
• Ferreira Ríos, Ivo. Oftalmólogo.
• Merchán B, Nelson L. Optómetra.
• Pérez Robles, Francisco. Licenciado en Optometría.
• Velázquez Guerrero, Rubén. Licenciado en Optometría.
• Velázquez Sánchez, Berenice. Licenciada en Optometría.
1. Garrec, A., Garrec, M. F., Catros, A., Belloir, D., Hurier, C., Mur, J., & Botaka, E. (1982). Evolution de la myopie d’enfants equipes de verres progressifs. Bulletin de La Societe Scientifique de Correction Oculaire S.S.C.O., 1, 105–110.
2. Leung, J. T., & Brown, B. (1999). Progression of myopia in Hong Kong Chinese schoolchildren is slowed by wearing progressive lenses. Optom Vis Sci, 76(6), 346–354.
3. Gwiazda, J. E., Hyman, L., Norton, T. T., Hussein, M. E., Marsh-Tootle, W., Manny, R., Wang, Y., Everett, D., & COMET Group (2004). Accommodation and related risk factors associated with myopia progression and their interaction with treatment in COMET children. Investigative ophthalmology & visual science, 45(7), 2143–2151.
4. Cheng, D., Woo, G. C., Drobe, B., & Schmid, K. L. (2014). Effect of bifocal and prismatic bifocal spectacles on myopia progression in children: three-year results of a randomized clinical trial. JAMA ophthalmology, 132(3), 258–264.
5. Bao J., Yang, A., Huang, Y., Li, X., Pan, Y., Ding, C., Lim, E.W., Zheng, J., Spiegel, D.P., Drobe, B., Lu, F., Chen, H. (2021). One-year myopia control efficacy of spectacle lenses with aspherical lenslets. British Journal of Ophthalmology.doi:10.1136/bjophthalmol-2020-318367
6. Bao, J., Huang, Y., Li, X., Yang, A., Zhou, F., Wu, J., Wang, C., Li, Y., Lim, E.W., Spiegel, D.P., Drobe, B., Chen, H., 2022. Spectacle Lenses With Aspherical Lenslets for Myopia Control vs Single-Vision Spectacle Lenses: A Randomized Clinical Trial. JAMA Ophthalmol. 140(5), 472–478.
7. Bullimore, Mark; Brennan, Noel. Myopia Control: Why Each Diopter Matters. Optometry and vision science: official publication of the American Academy of Optometry · May 2019
8. Mayo 2019. https://www.researchgate.net/publication/333266680_Myopia_Control_Why_Each_Diopter_Matters
9. Brien A Holden, Timothy R Fricke, David A Wilson, Monica Jong, Kovin S Naidoo, Padmaja Sankaridurg, Tien Y Wong, Thomas J Naduvilath, Serge Resnikoff . Global Prevalence of Myopia and High Myopia and Temporal Trends from 2000 through 2050. American Academy of Ophthalmology. 2016. https://pubmed.ncbi.nlm.nih.gov/26875007
10.Naidoo, Kovin. Blog: Myopia a Public Health Challenge that demands Optometry’s leadership. Published: 23.03.2021. https://www.iapb.org/blog/myopia-a-public-health-challenge-that-demands-optometrys-leadership/
11. Flitcroft, Ian. Global evidence-based effort makes inroads into improving clinical myopia management. https://www.pointsdevue.com/article/global-evidence-based-effort-makes-inroads-improving-clinical-myopia-management
12. Velázquez Guerrero, Ruben. Actualización en el control de la Miopía I. Revista Imagen Óptica No. 66. Año 16, Vol. 16, Nov-Dic, México 2014.
13. Myopia management in 2022. Dra. Kate Gifford. Plataforma Leonardo. Compañía EssilorLuxottica. https://leonardo.essilorluxottica.com/catalogue/subcatalogue/channel/myopia?courseDetail=co44851&courseTitle=myopia_management_in_2022
14. Xiong S, Sankaridurg P, Naduvilath T, Zang J, Zou H, Zhu J, Lv M, He X, Xu X. Time spent in outdoor activities in relation to myopia prevention and control: a meta-analysis and systematic review. Acta Ophthalmol. 2017 Sep;95(6):551-566.
15. MyKidsvision.org. Blog: Myopia Myths and treatments for short sightedness. https://www.mykidsvision.org/blog/myopia-myths-what-has-evidence/

16. https://worldcouncilofoptometry.info/advocacy/
17. Gifford Kate & Paul. Myopia Profile: Integration of Myopia Management in Clinical Practice. Plataformas Leonardo. Compañía EssilorLuxottica. https://leonardo.essilorluxottica.com/catalogue/ subcatalogue/channel/myopia?courseDetail=co41313&courseTitle=integrating_myopia_management_in_clinical_practice
Crizal® SapphireTM HR: Un escudo invisible para tus ojos y para tus lentes. Una promesa de transparencia, durabilidad, fácil cuidado y protección.




















La Cirugía Plástica Estética es una rama médica que se enfoca en mejorar la apariencia física del cuerpo para aquellos pacientes que deseen aumentar su confianza y bienestar emocional, a través de diversos procedimientos. Esta cirugía ofrece la posibilidad de realzar la belleza de forma segura y eficaz.
Existen varios procedimientos de este tipo de cirugías, como son:
• Cirugía nasal que se enfoca en mejorar la forma y tamaño de la nariz
• Cirugía de la mama ya sea aumento, disminución o elevar y remodelar los senos caídos.
• Cirugía abdominal para retirar el exceso de grasa y piel, así como, dar contorno a la cadera.
• Liposucción en diferentes áreas del cuerpo, con o sin lipo inyección de la misma grasa en otras áreas que se requiera aumento de volumen para moldear y dar diferente forma al cuerpo (Hoy llamada la lipoescultura).
• Cirugía de párpados.
• Cirugía de orejas.
• Cirugía facial.

• Cirugía de glúteos: de aumento, liposucción o levantamiento quirúrgico.
Recuerde que existen procedimientos estéticos no quirúrgicos siendo los más frecuentes:

• Aplicación de toxina botulínica para reducir las arrugar faciales (diferentes marcas comerciales).
• Aplicación de ácido hialurónico para dar aumento de volumen en diferentes áreas de la cara (diferentes marcas comerciales).
Se estimó que el mercado mundial de la cirugía estética tuvo un valor aproximado de 69 mil millones de dólares a nivel global en 2021, y se espera un importante aumento anual, llegando a alrededor de 155 mil millones de dólares para el año 2030.
En México, la cirugía estética es muy popular y el país se encuentra entre los lugares con más procedimientos estéticos a nivel mundial.


Si quiere llevar a cabo un procedimiento estético, es importante destacar que toda cirugía conlleva riesgos, y la Cirugía Plástica Estética no es la excepción. Por lo tanto, los pacientes que consideran someterse a un procedimiento estético tienen la obligación y responsabilidad de pensar en su propia seguridad.
Es por ello que, se suelen recomendar las siguientes pautas:
1. Seleccionar a un cirujano plástico certificado y con una reputación positiva en su práctica médica.
2. Comunicarse de forma clara y precisa con el cirujano para entender los alcances y limitaciones del procedimiento.
3. Comprender los riesgos y beneficios, y firmar un consentimiento informado para aprobar la cirugía.
4. Seguir todas las instrucciones preoperatorias de su médico, como exámenes de laboratorio, valoraciones cardiopulmonares, etc.
5. Informar sobre medicamentos o sustancias que se estén tomando y seguir las recomendaciones para dejar de fumar y limitar el consumo de alcohol.
Es fundamental que los pacientes hagan preguntas y aclaren todas sus dudas, así como mantener expectativas realistas sobre los resultados de la cirugía. De esta manera, se logrará una experiencia exitosa y se minimizarán los riesgos asociados.
Recuerda que escoger a tu cirujano es tu responsabilidad, infórmate bien y mantén una buena comunicación. Al seguir estas recomendaciones, obtendrás los mejores resultados en cualquier procedimiento estético que desees realizar, asegurando tu satisfacción y bienestar estético.
La Cirugía Plástica Estética puede mejorar tu vida, aumentar tu autoestima y brindarte una mayor confianza en ti mismo.













 Reg. Núm. 60619, SSA VI
Reg. Núm. 77930, SSA IV
Reg. Núm. 60619, SSA VI
Reg. Núm. 77930, SSA IV






La anemia se refiere a una disminución en la cifra de hemoglobina. Se define como:
Es la anemia más común en el mundo, sobre todo en mujeres en edad reproductiva (el embarazo y la menstruación), aunque también las pérdidas de sangre gastrointestinales, desnutrición y malabsorción son causa de este tipo de anemia. 2



Se diagnostica por medio de la biometría hemática, en donde comunmente encontraremos eritrocitos disminuidos y con un perfil de hierro, en donde se encuentran niveles bajos de hierro junto con índice de saturación bajo y ferritina, también disminuída junto con capacidad de fijación de hierro elevada.3
¿CÓMO SABER SI TENGO ANEMIA?
Los síntomas y signos comunes en la anemia dependerán del grado de la misma, pero en términos generales se puede presentar:
• Cansancio.
• Mareos.
• Dolores de cabeza.
• Palpitaciones.
• Molestias en mucosa oral como ardor.
• Fatiga o falta de aire con el esfuerzo (inclusive en reposo cuando es más grave).
• Caída de pelo.
• Uñas quebradizas.
• Falta de concentración.
• Somnolencia.
Las anemias carenciales constituyen un problema de salud global y son la primera causa de anemia en el mundo y un motivo de consulta frecuente. Dentro de este grupo de anemias las más comunes son por deficiencia de hierro, deficiencia de vitamina B12 y ácido fólico.1
Para determinar la existencia de la anemia, basta con realizar un estudio de biometría hemática. Si la cifra de hemoglobina es menor a la referida como normal, se debe buscar atención médica inmediata para determinar la causa.
Es fundamental determinar la causa de la deficiencia de hierro además de iniciar tratamiento de sustitución.2
La reposición de hierro se puede hacer vía oral o bien, vía parenteral en las personas que no toleren o no absorban adecuadamente el hierro oral. Se debe ver un aumento en la hemoglobina en las siguientes 2-4 semanas al inicio de tratamiento. Teóricamente, 500 mg de hierro absorbido debería de ser suficiente para aumentar la Hb en al menos 2 g/dl. Se deben de tomar en consideración en los pacientes que no responden al tratamiento oral que se continúe con pérdida sanguínea, malabsorción, mal apego al tratamiento.
FALLA AL TRATAMIENTO ORAL
Los pacientes con anemia por deficiencia de hierro en general presentan una mejoría en la cuenta de reticulocitos en los primeros 3-7 días del tratamiento, seguido de un aumento en la Hb en las siguientes 2-4 semanas. Sin embargo, en ocasiones, el aumento de la hemoglobina no es el esperado con el tratamiento de sustitución oral. Teóricamente, 500 mg de hierro absorbido debería de ser suficiente para aumentar la Hb en al menos 2 g/dl. Se deben de tomar consideraciones en los pacientes que no responden al tratamiento oral (p. ej. que el paciente continúe sangrando, mala absorción, revalorar el diagnóstico o mal apego al tratamiento).

TRATAMIENTO CON HIERRO INTRAVENOSO
El hierro parenteral está indicado cuando las pérdidas sanguíneas superan la capacidad de absorción del hierro, malabsorción, o que el tratamiento oral no sea suficiente o que sea poco tolerado. Existen varias presentaciones disponibles de hierro intravenoso: hierro sucrosa, gluconato férrico, carboximaltosa ferrica, hierro isomoltoside-1000, ferumoxytol, hierro dextran (de bajo peso molecular). 4

INHIBE LA ABSORCIÓN
Café, té, cereal, leche, fibra, bebidas carbonadas que contengan fosfato.
Multivitamínicos que contengan Calcio, Zinc, Magnesio o Cobre. Antiácidos, bloqueadores H2, inhibidores de la bomba de protones, quinolonas, tetracicilinas.
Referencias:
FACILITA LA ABSORCIÓN
Vitamina C, comidas ácidas, tabletas sin capa entérica, toma de los suplementos de hierro en ayuno.
2016;12(20):1136–47. Available from: http://dx.doi.org/10.1016/j.med.2016.10.002



















El enfoque Snoezelen se basa en la idea de proporcionar una serie de estimulaciones sensoriales controlada y adaptada a las necesidades individuales de cada persona con autismo. Los entornos Snoezelen están diseñados para ofrecer una amplia gama de estímulos sensoriales, como luces, colores, sonidos, texturas y aromas, que pueden ser ajustados y controlados según las preferencias y tolerancias de cada individuo. La estimulación sensorial controlada puede ayudar a explorar y regular sus respuestas sensoriales, promoviendo la relajación, la concentración y la calma.

Además, fomenta la interacción y la comunicación, mediante la creación de un entorno sensorialmente atractivo y seguro; motiva a los individuos a participar activamente y experimentar con los diferentes estímulos presentes. Esto fomenta la comunicación no verbal, así como el uso de gestos, expresiones faciales y vocalizaciones, así como también estimular el interés por establecer interacciones con los demás.
Sumado a lo anterior, ofrece un ambiente tranquilo y seguro donde los individuos pueden experimentar una relajación profunda y una disminu-
ción de la ansiedad. Los estímulos sensoriales suaves y controlados, combinados con la atmósfera calmante, pueden ayudar a reducir el estrés y promover un estado de relajación y bienestar general.
El enfoque Snoezelen no solo es ideal para la estimulación sensorial, de igual manera puede ser utilizado para promover el desarrollo cognitivo y para adquirir nuevas habilidades. En definitiva, los entornos Snoezelen ofrecen diferencias significativas en la calidad de vida de las personas con autismo.
































 Dra. Rocío C. Grajales Álvarez
Dra. Rocío C. Grajales Álvarez

El 60% de todos los casos de cáncer ocurre en pacientes mayores de 65 años y se espera un incremento del 70% de casos de cáncer en los próximos 30 años1 . El cáncer de mama es el más frecuente en la mujer, con más de 2.2 millones de casos nuevos en 20202
En México, se estimó un 15.5% de mayores de 65 años en una revisión de más de 5,400 pacientes con cáncer de mama3 y hacia 2021, se reportaron casi 8,000 muertes por esta enfermedad en nuestro país, equivalente al 8.8% de las muertes por cáncer, siendo la primera causa de mortalidad por cáncer en mujeres4
El tratamiento del cáncer de mama está determinado por la etapa clínica y el perfil molecular tumoral y puede incluir diversas modalidades como cirugía, radioterapia,
quimioterapia, terapia antihormonal, terapia blanco molecular e inmunoterapia. A pesar del incremento en la incidencia de cáncer en la población geriátrica, existe escasa evidencia para guiar las decisiones terapéuticas oncológicas en este grupo etario, ya que de acuerdo con cifras del National Cancer Institute (NCI) Cooperative Group Clinical Trials de Estados Unidos, menos del 25% de los pacientes incluidos en ensayos clínicos tienen 65 a 74 años y sólo el 10% es mayor de 75 años5. Esto se refleja en un sobretratamiento a pacientes menos aptas, y subtratamiento para aquéllas en buenas condiciones para llevar un manejo oncológico completo.
En el ámbito oncológico, suele considerarse la edad cronológica en la toma de decisiones, así como el estado funcional basado en Karnofsky Performance Status
La valoración geriátrica integral (CGA, por sus siglas en inglés: Comprehensive Geriatric Assessment) es una evaluación funcional y fisiológica del paciente geriátrico, que ha demostrado un impactante pronóstico en supervivencia y riesgo de toxicidades7-8 facilitando la toma de decisiones y recomendando intervenciones que ayuden a mejorar la tolerancia, el apego a tratamiento y la calidad de vida9. La CGA detecta problemas médicos, psicosociales y funcionales no detectados en una consulta rutinaria. Los dominios que abarca incluyen: estado funcional, problemas psicológicos, polifarmacia, comórbidos, nutrición, apoyo social y déficit cognitivo, identificando áreas de vulnerabilidad asociados a peores desenlaces en pacientes con cáncer 10. Se ha demostrado que las intervenciones derivadas de la CGA tienen impacto en la reducción de mortalidad, mejoría del estado funcional y reducción de ingresos hospitalarios en
o la escala de ECOG (Eastern Cooperative Oncology Group) sin tomar en cuenta su edad funcional, en otras palabras, dentro del contexto integral del paciente geriátrico que incluye comórbidos, síndromes geriátricos, deterioro cognitivo, deterioro funcional, depresión y entorno social6
Por lo tanto, y asumiendo el impacto funcional que implican un tratamiento oncológico, se han elaborado diversas herramientas que ayudan a estimar la expectativa de vida, tolerancia y complicaciones asociadas los tratamientos, considerando los factores psicosociales y médicos de cada paciente.
pacientes con cáncer 11-12. La CGA detecta hasta un 70% de problemas no detectados en la práctica rutinaria que pueden mejorar con maniobras derivadas de la misma. Como resultado de lo anterior, se ha demostrado que una CGA puede cambiar la decisión terapéutica en oncología hasta en un 50% de los pacientes 13-16. Derivado de una CGA, se clasifica a los pacientes geriátricos en sanos, vulnerables y frágiles, de acuerdo a lo cual pueden considerarse aptos para manejo oncológico, pacientes en quienes hay que realizar intervenciones o ajustes de manejo, y aquellos no candidatos a tratamiento que se benefician únciamente de cuidados paliativosTabla 1 y 17
No obstante la utilidad de la CGA, no es realizada de forma rutinaria en la consulta oncológica general, debido al tiempo requerido y la necesidad de un médico geriatra18. Por tanto, se han desarrollado diversas herramientas de uso sencillo y rápido, que ofrecen información general sobre el estado funcional del paciente geriátrico, con el fin de que cualquier médico no-geriatra pueda llevarla al cabo como tamizaje para aquellos pacientes que requieran una valoración geriátrica integral.19-20
G8Tabla 2 es una herramienta de tamizaje geriátrico para detectar fragilidad con una sensibilidad de un 85% y especificidad del 64%, siendo la más sensible21, Incluye los dominios: estado nutricional (ingesta, pérdida ponderal, índice de masa corporal), movilidad, estado psicológico, polifarmacia, autopercepción de estado de salud y edad; y estratifica a las pacientes de acuerdo a su puntaje en: >14, paciente sana, que no amerita intervenciónes; y <14, paciente vulnerable/ frágil que requiere una evaluación geriátrica integral. El cuestionario es práctico y toma menos de 3 minutos su elaboración. Está demostrado que los resultados anormales en las herramientas de tamizaje geriátrico se asocian a un impacto negativo en el estado funcional y menor supervivencia22-27. Se estima que entre un 20 a un 50% de la población tamizada, tendrá un G8 con criterios de fragilidad.
Las Guías Norteamericanas de la Red Nacional Integral del Cáncer (NCCN: National Comprehensive Cancer Network), de la Sociedad Americana de Oncología Clínica
(ASCO: American Society of Clinical Oncology) y las de la Sociedad Internacional de Oncología Geriátrica (SIOG) y (28 – 30) recomiendan realizar una CGA en todas las pacientes >65 que recibirán quimioterapia e incluyen G8 como parte de las herramientas de tamizaje geriátrico como perdictor de mortalidad.31-32
Recientemente, el Consenso Mexicano para el Diagnóstico y Tratamiento del Cáncer Mamario ha agregado la realización del cuestionario G8 como parte de la evaluación de las pacientes geriátricas con cáncer de mama33. Por tanto, debemos considerar herramientas que faciliten a médicos no geriatras a diferenciar pacientes que no son candidatos a manejos oncológicos de quienes pudieran obtener beneficio del tratamiento sin importar su edad cronológica.34-36
El tamizaje geriátrico debe ser realizado por todo oncólogo en contacto con pacientes ancianos de manera rutinaria, con el fin de identificar problemas no observados en la práctica diaria.
Sano Vulnerable Fragil Sin anormalidades. Independencia en actividades de la vida diaria.
Pérdida de peso 5 – 10%. Pobre apoyo social. Historia de caídas.
¿Ha disminuido la ingesta de alimentos en los últimos tres meses debido a la pérdida de apetito, problemas digestivos o dificultades para masticar o tragar?
Pérdida de peso involuntaria en los últimos 3 meses
Movilidad
Problemas neuropsicológicos
Índice de masa corporal (IMC) (peso en kg / estatura en m2)
¿Toma más de tres medicamentos por día?
En comparación con otras personas de su edad ¿cómo considera el paciente su estado de salud?
Edad
Dependencia en actividades de la vida diaria. Comorbilidades severas. Deterioro cognitivo moderado a severo. TUG >20 seg. Tratamiento estándar. Intervenciones para mejorar cuestiones reversibles. Tratamientos modificados. Considerar potencial. tratamiento estándar.
0 = ha comido mucho menos
1 = ha comido menos
2 = ha comido igual
0 = pérdida de peso > 3 kg
1 = no lo sabe
Manejo paliativo.
2 = pérdida de peso entre 1 y 3 kg
3 = sin pérdida de peso
0 = en cama o silla de ruedas
1 = capaz de levantarse de la cama/silla, pero no sale a la calle
2 = sale a la calle
0 = demencia o depresión graves
1 = demencia leve
2 = sin problemas psicológicos
0 = IMC <19
1 = IMC entre 19 y <21
2 = IMC entre 21 y <23
3 = IMC ≥23
0 = si

1 = no
0 = no tan bueno
0.5 = no sabe
1 = igual de bueno
2 = mejor
0 = >85 años
1 = 80-85 años
2 = <80 años
Poh Loh, K., Soto-Perez-de-Celis, E., Hsu, T., Nienke A. de Glas, Matteo, N., Battisti, L., Baldini, C., Rodrigues, M., Lichtman, S., and Wildiers, H. What Every Oncologist Should Know About Geriatric Assessment for Older Patients With Cancer: Young International Society of Geriatric Oncology Position Paper. J Oncol Pract 2018; 14(2): 85 – 94. Hamaker, ME., Vos, AG., Smorenburg, CH., et al: The value of geriatric assessments in predicting treatment tolerance and all-cause mortality in older patients with cancer. Oncologist 2012; 17: 1439-1449. Stuck, AE., Siu, AL., Wieland, GD., Adams, J., Rubenstein, LZ. Comprehensive geriatric assessment: a meta-analysis of controlled trials. Lancet 1993; 342: 1032–6.
Cohen, HJ., Feussner, JR., Weinberger, M., et al. A controlled trial of inpatient and outpatient geriatric evaluation and management. N Engl J Med 2002; 346: 905–12. http://dx.doi.org/10.1056/ NEJMsa010285. Hamaker, ME., Schiphorst, AH., ten Bokkel Huinink, D., et al: The effect of a geriatric evaluation on treatment decisions for older cancer patients—A systematic review. Acta Oncol 2014; 53: 289-296. Decoster, L., Kenis, C., Van Puyvelde, K., et al: The influence of clinical assessment (including age) and geriatric assessment on treatment decisions in older patients with cancer. J Geriatr Oncol 2013; 4: 235-241. Yokom, D. Geriatric oncology screening tools for CGA-based interventions: results from a phase II study of geriatric assessment and management for older adults with cancer. J Geriatr Oncol 2018. Article in press. Caillet, P. Optimal management of elderly cancer patients: usefulness of the Comprehensive Geriatric Assessment. Clin Int in Aging 2014; 9: 1645-60.
Hernández, C. Comprehensive geriatric assessment in the older adult with cancer:
(SIOG). Crit Rev Oncol Hematol 2005; 55: 241-252. Overcash, JA., Beckstead, J., Extermann, M., et al: The abbreviated comprehensive geriatric assessment (aCGA): A retrospective analysis. Crit Rev Oncol Hematol 2005; 54: 129-136. Hamaker ME, Wildes TM, Rostoft S: Time to stop saying geriatric assessment is too time consuming. J Clin Oncol 2017; 35: 2871-2874.
I.C. vanWalree, E. Scheepers, L.H. van Huis-Tanja, et al., A systematic review on the association of the G8 with geriatric assessment, prognosis and course of treatment in older patients with cancer. J Geriatr Oncol 2019; 8: pii: S1879-4068(19)30099-2. doi: 10.1016/j.jgo.2019.04.016. Aaldriks, AA., Giltay, EJ., le Cessie, S., et al: Prognostic value of geriatric assessment in older patients with advanced breast cancer receiving chemotherapy. Breast 2013; 22: 753-760. Bellera, CA., Rainfray, M., Mathoulin-P´elissier, S., et al: Screening older cancer patients:



















